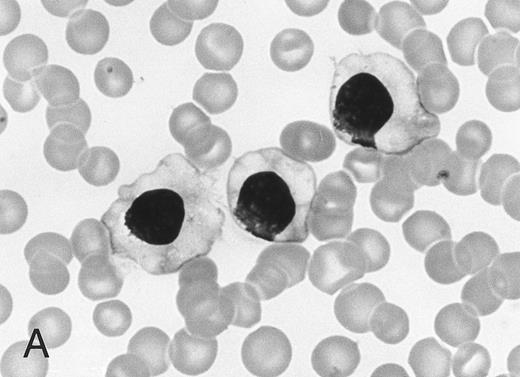
Fig. 1. Morphology of peripheral blood mononuclear cells in HBLD (A) and in HCL-Japanese variant. (B). (May-Grünwald-Giemsa.)

Abstract
Polyclonal B lymphocytosis was found in four patients having clinical and hematologic features resembling those of hairy cell leukemia (HCL). All four patients were women between 37 and 67 years of age. Three patients had splenomegaly. Lymphadenopthy was absent or slight. Persistent lymphocytosis was seen in all the patients, and anemia and/or thrombopenia was observed in three of the patients. Abnormal lymphocytes have long microvilli and prominent membranous ruffles on their surfaces. Bone marrow aspirates and biopsy specimens showed increased numbers of abnormal lymphocytes with round nuclei and abundant pale cytoplasm. Although these findings were similar to those of HCL, studies of Ig gene rearrangements and expression showed the polyclonal proliferation of B cells. We called this new disease hairy B-cell lymphoproliferative disorder (HBLD). All four patients exhibited a polyclonal increase in serum IgG. The morphology of the cells in HBLD was more similar to that of leukemia cells of a variant form of HCL (HCL-Japanese variant) than to typical HCL cells. The surface IgG+, CD5−, CD11c+, CD22+, CD24−, CD25− phenotype and the weak tartrate-resistant acid phosphatase activity in the cells were identical to those of HCL cells of the Japanese variant. Our findings suggest that the B cells in HBLD are the nonmalignant counterpart of leukemic B cells in HCL-Japanese variant.
HAIRY CELL LEUKEMIA (HCL) is a well-defined clinicopathologic entity.1 Patients with HCL have isolated splenomegaly and pancytopenia. Circulating abnormal mononuclear cells have hairy cytoplasmic projections, strong tartrate-resistant acid phosphatase activity, and a CD11c+, CD22+, CD25+ phenotype.1-4
However, most Japanese patients with HCL have features that differ considerably from those of typical HCL seen in western countries.5,6 We have characterized a distinct HCL subtype that is seen in many patients with HCL in Japan and was thus called HCL-Japanese variant.7 HCL-Japanese variant has many features in common with typical HCL but differs in several aspects.
Patients with HCL-Japanese variant exhibit splenomegaly and minimal lymphadenopathy. The abnormal mononuclear cells have long microvilli and prominent membranous ruffles, as seen under the phase-contrast and scanning electron microscope. The histopathologic features of these patients are also consistent with those of HCL. However, the majority of patients with HCL-Japanese variant were shown to have a moderate degree of leukocytosis, unlike the leukopenia frequently seen in typical HCL. In May-Giemsa–stained smears, the abnormal lymphocytes have densely stained, round nuclei and abundant pale cytoplasm with slightly serrated edges. The tartrate-resistant acid phosphatase activity of these cells is weak. In addition to these findings, the abnormal cells had a CD5−, CD11c+, CD25− phenotype, which differs from that of both typical HCL and chronic lymphocytic leukemia.7
We recently evaluated four patients with chronic B-cell lymphocytosis with features resembling HCL. The clinical and hematologic findings of these patients were practically indistinguishable from those of HCL-Japanese variant. However, studies on the expression of the surface Ig and the rearrangement of the Ig genes showed that the proliferation of B cells in these patients was polyclonal. The features of this disease, which we called hairy B-cell lymphoproliferative disorder (HBLD), also differed from those of persistent polyclonal B lymphocytosis (PPBL), which were reported by Gordon et al.8
PATIENTS
The clinical and hematologic data of the four patients with HBLD are summarized in Table 1. All patients were women between 37 and 67 years of age. They had no complaints or only minor complaints, and none was a smoker. Physical examination showed splenomegaly in three of the patients, including one patient (case no. 3) whose spleen was large and palpable under the umbilical line. Lymphadenopathy was either absent or only slight. Laboratory examinations showed lymphocytosis (4,932 to 21,252/μL) in all four patients. Three of the patients had anemia (hemoglobin level, <11 g/dL) and/or thrombopenia (<110 × 109/L). Prominent polyclonal hypergammaglobulinemia was observed in all four patients. Serum IgG levels were high in all four patients, and high levels of IgA and/or IgM were detected in three of the patients. Antibodies against human T-cell leukemia virus type I (HTLV-I) were not detected in any of the four patients. Antibodies against human immunodeficiency virus I (HIV-I) were negative in the three patients tested. Serologic assays for antibodies to Epstein-Barr virus (EBV) showed a pattern of past infection (virus capsid antigen-IgG+, -IgM−, Epstein-Barr nuclear antigen-positive).
Three patients (cases no. 1, 2, and 4) were observed for 20 to 48 months without therapy. The clinical and hematologic features in cases no. 1 and 2 showed no remarkable changes during the observation period, whereas one patient (case no. 4) exhibited a gradual increase in spleen size accompanied by a slight but significant decrease in hemoglobin concentration (from 9.6 to 8.7 g/dL) and platelet count (from 140 to 121 × 109/L). Although we could not follow the clinical course of case no. 3, she had been incidentally found to have leukocytosis (26,200/μL) 10 months before she was referred to our institute.
Morphology of peripheral blood mononuclear cells in HBLD (A) and in HCL-Japanese variant. (B). (May-Grünwald-Giemsa.)
Morphology of peripheral blood mononuclear cells in HBLD (A) and in HCL-Japanese variant. (B). (May-Grünwald-Giemsa.)
MATERIALS AND METHODS
Cell morphology was studied on May-Grünwald-Giemsa–stained smears by light microscopy and in wet films by phase-contrast microscopy, as previously described.9 The ultrastructure of cells was examined under a scanning electron microscope. A cytochemical test for tartrate-resistant acid phosphatase activity was performed by the fast Garnet GBC method.10
Mononuclear cells were isolated from heparinized peripheral blood by Ficoll-Hypaque density gradient centrifugation. Membrane antigens were stained by direct immunofluorescence using fluorescein isothiocyanate (FITC)- or phycoerythrin (PE)-conjugated CD2, CD5, CD11c, CD19, CD22, and CD25 monoclonal antibodies (MoAbs; Becton Dickinson, Mountain View, CA). CD24 was detected by indirect immunofluorescence using a L30 MoAb11 (Seikagaku Co, Tokyo, Japan) and FITC-conjugated goat antimouse IgG. Detection of surface Ig (SIg) was performed by direct immunofluorescence using FITC-conjugated F(ab)2 fragments of goat antihuman Ig heavy and light chains (Bio Source International, Camarillo, CA) or a mixture of FITC-conjugated anti-Igκ and PE-conjugated anti-Igλ MoAbs (Becton Dickinson). Before staining, mononuclear cells were cultured at 37°C for 8 hours and then extensively washed to remove exogenous Ig. Results from the immunofluorescence tests were obtained using a fluorescence-activated cell sorting (FACS) analyzer (Becton Dickinson). HLA DR typing was performed with the standard National Institutes of Health micro-cytotoxicity test.12
For the analysis of Ig and T-cell receptor (TCR) genes, high molecular weight DNA was prepared from mononuclear cells and digested with the appropriate restriction enzymes, and the products were electrophoresed and transferred to a hybridization membrane. The filters were hybridized with the following 32P-labeled probes: (1) a 5.6-kb BamHI-HindIII genomic fragment, including the JH 1-6 sequences of the Ig heavy chain gene cluster; (2) a 1.1-kb genomic fragment corresponding to the Jκ gene cluster (Oncor Inc, Gaithersburg, MD); and (3) a Cβ probe, which detects both the Cβ1 and Cβ2 regions of the TCR (Oncogene Science, Cambridge, MA). The filters were washed under stringent conditions and autoradiographed.
(A) Phase-contrast micrograph of peripheral blood lymphocytes in HBLD. The cells display striking surface projections. (B) Scanning electron micrograph shows prominent ruffles and long microvilli.
(A) Phase-contrast micrograph of peripheral blood lymphocytes in HBLD. The cells display striking surface projections. (B) Scanning electron micrograph shows prominent ruffles and long microvilli.
Ig gene rearrangements were also studied by polymerase chain reaction (PCR). The complementarity determining region 3 (CDR3) and adjacent segments of Ig heavy chain genes were amplified using the following consensus primers: 5′-CACTGAATTCGACACGGCCGTGTATTACTGTG-3′ recognizing the third framework region of the variable (VH) segments of the Ig heavy chain genes and 5′-TACAGGATCCTGAGGAGACGGTGACCAGGG-3′, which is capable of hybridizing to the 3′ portion of the joining (JH) segments.13 The PCR reaction mixtures (50 μL) contained 0.1 mmol/L each of deoxyadenosine triphosphate, deoxycytidine triphosphate, thymidine triphosphate, and deoxyguanosine triphosphate; 12.5 pmol of each primer; 375 ng template DNA; 1× Taq buffer (10 mmol/L Tris-HCl, 50 mmol/L KCl, 1.5 mmol/L MgCl2 ); and 1.5 U recombinant Taq DNA polymerase (Takara Co, Otsu, Japan). PCR amplification was performed for 30 cycles consisting of denaturation at 95°C for 1 minute and 20 seconds, annealing at 60°C for 1 minute, and elongation at 72°C for 1 minute and 30 seconds. Amplified DNA was electrophoresed on a 10% polyacrylamide gel in TBE buffer (89 mmol/L Tris, 89 mmol/L boric acid, 2 mmol/L EDTA) and visualized under UV light after ethidium bromide staining.
The effect of 12-O-tetradecanoylphorbol-13-acetate (TPA) on the peripheral blood lymphocytes of the patients with HBLD was studied as previously described.14 In brief, mononuclear cells were incubated for 72 hours in the presence of 100 ng/μL TPA, and morphologic changes in the TPA-treated cells were then evaluated under an inverted microscope.
RESULTS
The cell morphology of lymphocytes in the May-Grünwald-Giemsa–stained blood films of patients with HBLD is shown in Fig 1A. Most lymphocytes were larger than chronic lymphocytic leukemia lymphocytes and had abundant, pale cytoplasm with smooth or slightly serrated edges. The nucleus was round and contained densely aggregated nuclear chromatin and an indistinct nucleolus. The morphology of the cells was quite similar to that of the leukemia cells of the HCL-Japanese variant shown in Fig 1B. Most lymphocytes in HBLD had many long surface villi and prominent membranous ruffles, as shown by phase-contrast microscopy and scanning electron microscopy (Fig 2A and B). This surface morphology is characteristic of hairy cells of both typical HCL and HCL-Japanese variant.7 Tartrate-resistant acid phosphatase activity was detected in a proportion of the lymphocytes, although the reaction was significantly weaker than in the hairy cells of typical HCL.
Bone marrow aspirates exhibited lymphocytosis and contained many abnormal lymphocytes with the same morphologic features as lymphocytes in the peripheral blood. Biopsy specimens of bone marrow obtained from two patients (cases no. 1 and 3) showed that abnormal mononuclear cells with round nuclei and abundant pale cytoplasm were scattered throughout the tissue and occasionally formed clusters of variable sizes.
The immunophenotypic findings are summarized in Table 2. Most of the lymphocytes in HBLD expressed the CD11c, CD19, and CD22 antigens. However, lymphocytes were not stained by the anti-CD24 or anti-CD25 antibodies. The proportion of cells staining with anti-CD5 paralleled the findings with anti-CD2, showing that the B cells did not express the CD5 antigen.
The expression of SIg light chains was investigated by two-color immunofluorescence, using FITC-conjugated anti-Igκ and PE-conjugated anti-Igλ. As shown in Table 2, the numbers of both κ+ and λ+ lymphocytes were abnormally high in patients with HBLD. The differences in FACS analyzer profiles between HBLD and HCL-Japanese variant are shown in Fig 3. The majority of B cells in HBLD expressed the γ-heavy chain isotype, whereas a few lymphocytes expressed the μ-chain.
Two-color immunofluorescence analysis of Igκ and Igλ expression on the cells of patients with HBLD and a patient with HCL-Japanese variant. (A through D) HBLD (cases no. 1 through 4); (E) HCL-Japanese variant.
Two-color immunofluorescence analysis of Igκ and Igλ expression on the cells of patients with HBLD and a patient with HCL-Japanese variant. (A through D) HBLD (cases no. 1 through 4); (E) HCL-Japanese variant.
The rearrangements of the Ig heavy chain (JH) and κ chain (Jκ) genes were studied in the four patients, and the TCR (TCRβ) genes were examined in three patients. None had rearranged JH, Jκ, or TCRβ genes, as shown by Southern blot analysis. The configuration of the Ig heavy chain genes in HBLD and in HCL-Japanese variant is shown in Fig 4. We also studied Ig gene rearrangements by PCR amplification of the CDR3 region using the VH and JH consensus primers. As shown in Fig 5, the amplified samples from all four patients with HBLD showed a smear of variably sized PCR products. These immunophenotypic and Ig gene rearrangement studies showed that the B cells of patients with HBLD increased polyclonally.
Rearrangement of Ig heavy chain in HBLD and in HCL-Japanese variant. DNA extracted from mononuclear cells was digested with (A) EcoRI or (B) HindIII restriction enzyme and hybridized to a JH probe. Rearranged bands are indicated by arrows, and germ lines are indicated by dashes. Lane C, normal placenta; lanes 1 through 4, HBLD (cases no. 1 through 4); lane 5, HCL-Japanese variant.
Rearrangement of Ig heavy chain in HBLD and in HCL-Japanese variant. DNA extracted from mononuclear cells was digested with (A) EcoRI or (B) HindIII restriction enzyme and hybridized to a JH probe. Rearranged bands are indicated by arrows, and germ lines are indicated by dashes. Lane C, normal placenta; lanes 1 through 4, HBLD (cases no. 1 through 4); lane 5, HCL-Japanese variant.
PCR amplification of Ig heavy chain gene using the consensus VH and JH primers. PCR products from patients with HBLD (cases no. 1 through 4) showed a diffuse smear, indicating a polyclonal B-cell population (lanes 1 through 4). Lane 5, positive control (a patient with precursor B-cell acute lymphocytic leukemia); lane 6, negative control (placental DNA); lane M, size markers.
PCR amplification of Ig heavy chain gene using the consensus VH and JH primers. PCR products from patients with HBLD (cases no. 1 through 4) showed a diffuse smear, indicating a polyclonal B-cell population (lanes 1 through 4). Lane 5, positive control (a patient with precursor B-cell acute lymphocytic leukemia); lane 6, negative control (placental DNA); lane M, size markers.
We investigated the HLA-DR phenotypes of HBLD patients and compared them with those of patients with persistent polyclonal B lymphocytosis8 in which an association with the HLA-DR7 phenotype was found. None of our patients had a DR-7 phenotype, and three of four patients expressed DR4.
Leukemic hairy cells underwent profound morphologic changes when treated with TPA.14 15 We studied the morphology of cultured lymphocytes from three patients with HBLD in the presence of TPA. After short-term culture, 22.0% to 75.5% of the lymphocytes underwent morphologic changes and had a fibroblast-like elongated shape. Such a transformation was also seen in normal, TPA-treated, peripheral blood lymphocytes but was only observed in a very small proportion of these cells (<1%).
DISCUSSION
The clinical and hematologic findings from the four patients with HBLD were quite similar to those from the HCL-Japanese variant.7 The patients with HBLD had splenomegaly and minimal lymphadenopathy. Persistent lymphocytosis was seen in all the patients, and slight to moderate degrees of anemia with or without thrombopenia were seen in three of the patients. The morphology of the lymphocytes in these patients under the light microscope and scanning electron microscope were, in fact, indistinguishable from that of leukemic B cells of HCL-Japanese variant. The histopathologic findings from the bone marrow were also similar to those described for HCL.16
The B cells of patients with HBLD had a CD5−, CD11c+, CD25− phenotype and had IgG on their surfaces. These phenotypic features, including the heavy chain isotype of SIg in HBLD, are also seen in HCL-Japanese variant.7 The CD24 antigen was not detected on the B cells of our patients. This B-cell antigen has a wide spectrum of reactivity with normal and leukemic B cells, but it is rarely detected in typical HCL.17,18 We recently found that leukemic B cells of HCL-Japanese variant were also CD24−.19
Studies on the expression of the Ig light chains and the rearrangement of the Ig genes by Southern blotting and PCR amplification showed that the B cells in HBLD increased polyclonally. Gordon et al8 described a benign lymphoproliferative disorder (PPBL) in three patients that was characterized by polyclonal B lymphocytosis with binucleated lymphocytes. Since then, 25 cases of PPBL have been reported in western countries.20-27 All of the patients with PPBL so far were female and smoked. Serum IgM levels are always high, and serum levels of IgA and IgG are often low. Many patients do not have splenomegaly or lymphadenopathy, and none showed anemia or thrombopenia. Interestingly, the majority of these patients have the HLA-DR7 phenotype.
The clinical and laboratory findings from our patients were significantly different from those of PPBL patients. None of our patients was a smoker. Few binucleated lymphocytes were seen in our patients, whereas features resembling HCL were not observed in PPBL. The B cells of our patients expressed the CD11c antigen, which was not detected in PPBL patients, as shown in a recent report by Troussard et al.25 Although polyclonal hypergammaglobulinemia is seen in both groups of patients, the high levels of IgG in our patients differ from the high levels of IgM and low levels of IgG seen in PPBL patients. Furthermore, three of four patients in our study expressed HLA-DR4, and none had the HLA-DR7 phenotype. These findings show that HBLD may be closely related to PPBL but is distinct from the latter. Very recently, another Japanese patient with polyclonal B lymphocytosis was reported.28 This patient was also referred to our institute under a diagnosis of chronic lymphocytic leukemia, and we detected the same features as described for the patient with HBLD.
Several groups have shown that hairy cells underwent morphologic changes into a fibroblast-like elongated shape after short-term culture with TPA.14,15 This morphologic change is rarely seen in B-cell leukemias other than HCL, including the Japanese variant. In this study, we found that B cells in patients with HBLD were also transformed into an elongated shape by TPA treatment. Thus, all our findings on the B cells of HBLD are identical or quite similar to those of hairy cells in HCL-Japanese variant, except for the polyclonal proliferation seen in HBLD. These findings strongly suggest that the B cells that were increased in the peripheral blood of our patients were a nonmalignant counterpart of the leukemic B cells of HCL-Japanese variant. Previously, we have reported that surface IgG-bearing lymphocytes in normal peripheral blood have cytologic and cytochemical similarities to hairy cells, and we suggested that this small population might be the normal counterpart of hairy cells.9 Our findings suggest that HBLD results from the abnormal proliferation of IgG-bearing lymphocytes; this idea also supports our previous findings.
The etiology of HBLD remains elusive. Smoking is unrelated to HBLD. All four patients with HBLD were women, and three had the HLA-DR4 phenotype. These findings suggest the involvement of some genetic disposition in HBLD, but further study is required in a larger patient population. EBV infection is responsible for polyclonal lymphoproliferative disorders in patients with immunodeficiency.29 However, an immunodeficient state was not seen in our patients; antibodies against HIV were also not seen. Serologic assays for antibodies against EBV in our patients suggest a past, but not acute or persistent, EBV infection. In addition, the EBV genome was not detected by PCR amplification in mononuclear cells obtained from two patients with HBLD (data not shown). Katayama et al30 reported that HTLV-I–associated antibodies were detected in the sera of Japanese patients with HCL. With a sensitive Western blot assay, we could not detect antibodies against HTLV-I in patients with HBLD. HTLV-II has been detected in a rare lymphoproliferative disorder called T-cell HCL31 and in a proportion of intravenous drug abusers.32 Although we did not perform assays for antibodies to HTLV-II, it is unlikely that our patients had HTLV-II antibodies, because antibodies against HTLV-I cross-react with HTLV-II.33
The insidious onset of the disease and the large spleen or an increasing splenomegaly accompanied by cytopenias seen in two patients with HBLD suggest the progressive course of the disease, although the process is very slow. Whether HBLD develops into HCL needs to be clarified; however, a longer observation period is needed to elucidate the ultimate outcome.
ACKNOWLEDGMENT
We are indebted to Dr H. Asada (Osaka University Medical School) for detecting the EBV genome. We also thank Dr K. Shiomi for providing us with samples from a patient under his care.
Address reprint requests to Takashi Machii, MD, Hematology and Oncology, Osaka University Medical School, 2-2 Yamadaoka, Suita, Osaka 565, Japan.